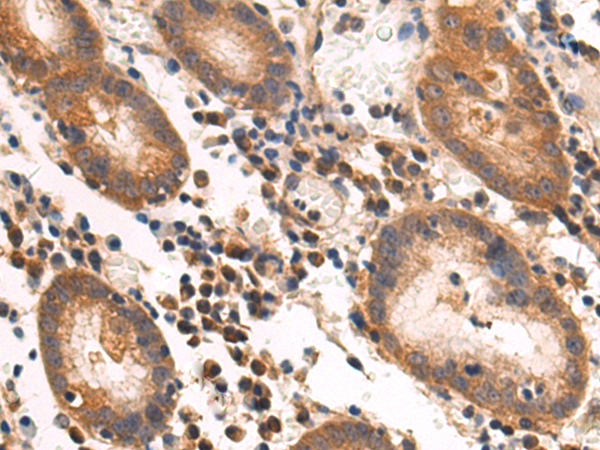

别名:CHIP; SCA48; UBOX1; SCAR16; HSPABP2; NY-CO-7; SDCCAG7应用:WB,IHC
反应种属:Human, Mouse
规格:50μl/100μl
| Description |
|---|
| This gene encodes a protein containing tetratricopeptide repeat and a U-box that functions as a ubiquitin ligase/cochaperone. The encoded protein binds to and ubiquitinates shock cognate 71 kDa protein (Hspa8) and DNA polymerase beta (Polb), among other targets. Mutations in this gene cause spinocerebellar ataxia, autosomal recessive 16. Alternative splicing results in multiple transcript variants. There is a pseudogene for this gene on chromosome 2. |
| Specification | |
|---|---|
| Aliases | CHIP; SCA48; UBOX1; SCAR16; HSPABP2; NY-CO-7; SDCCAG7 |
| Swissprot | Q9UNE7 |
| WB Predicted band size | 35 kDa |
| Host/Isotype | Rabbit IgG |
| Storage | Store at 4°C short term. Aliquot and store at -20°C long term. Avoid freeze/thaw cycles. |
| Species Reactivity | Human, Mouse |
| Immunogen | Fusion protein of human STUB1 |
| Formulation | pH7.4 PBS, 0.05% NaN3, 40% Glycerol |
| Application | |
|---|---|
| WB | 1/1000-1/5000 |
| IHC | 1/50-1/200 |
| ELISA | 1/5000-1/10000 |
![]() |
Gel: 8%SDS-PAGE, Lysate: 40 μg, Lane: 293T cell lysate, Primary antibody: P03662(STUB1 Antibody) at dilution 1/1000, Secondary antibody: Goat anti rabbit IgG at 1/5000 dilution, Exposure time: 10 seconds |
![]() |
The image is immunohistochemistry of paraffin-embedded Human liver cancer tissue using P03662(STUB1 Antibody) at dilution 1/75. (Original magnification: ×200) |
![]() |
The image is immunohistochemistry of paraffin-embedded Human gastric cancer tissue using P03662(STUB1 Antibody) at dilution 1/75. (Original magnification: ×200) |
本公司的所有产品仅用于科学研究或者工业应用等非医疗目的,不可用于人类或动物的临床诊断或治疗,非药用,非食用。
暂无评论
本公司的所有产品仅用于科学研究或者工业应用等非医疗目的,不可用于人类或动物的临床诊断或治疗,非药用,非食用。
中文

发表回复